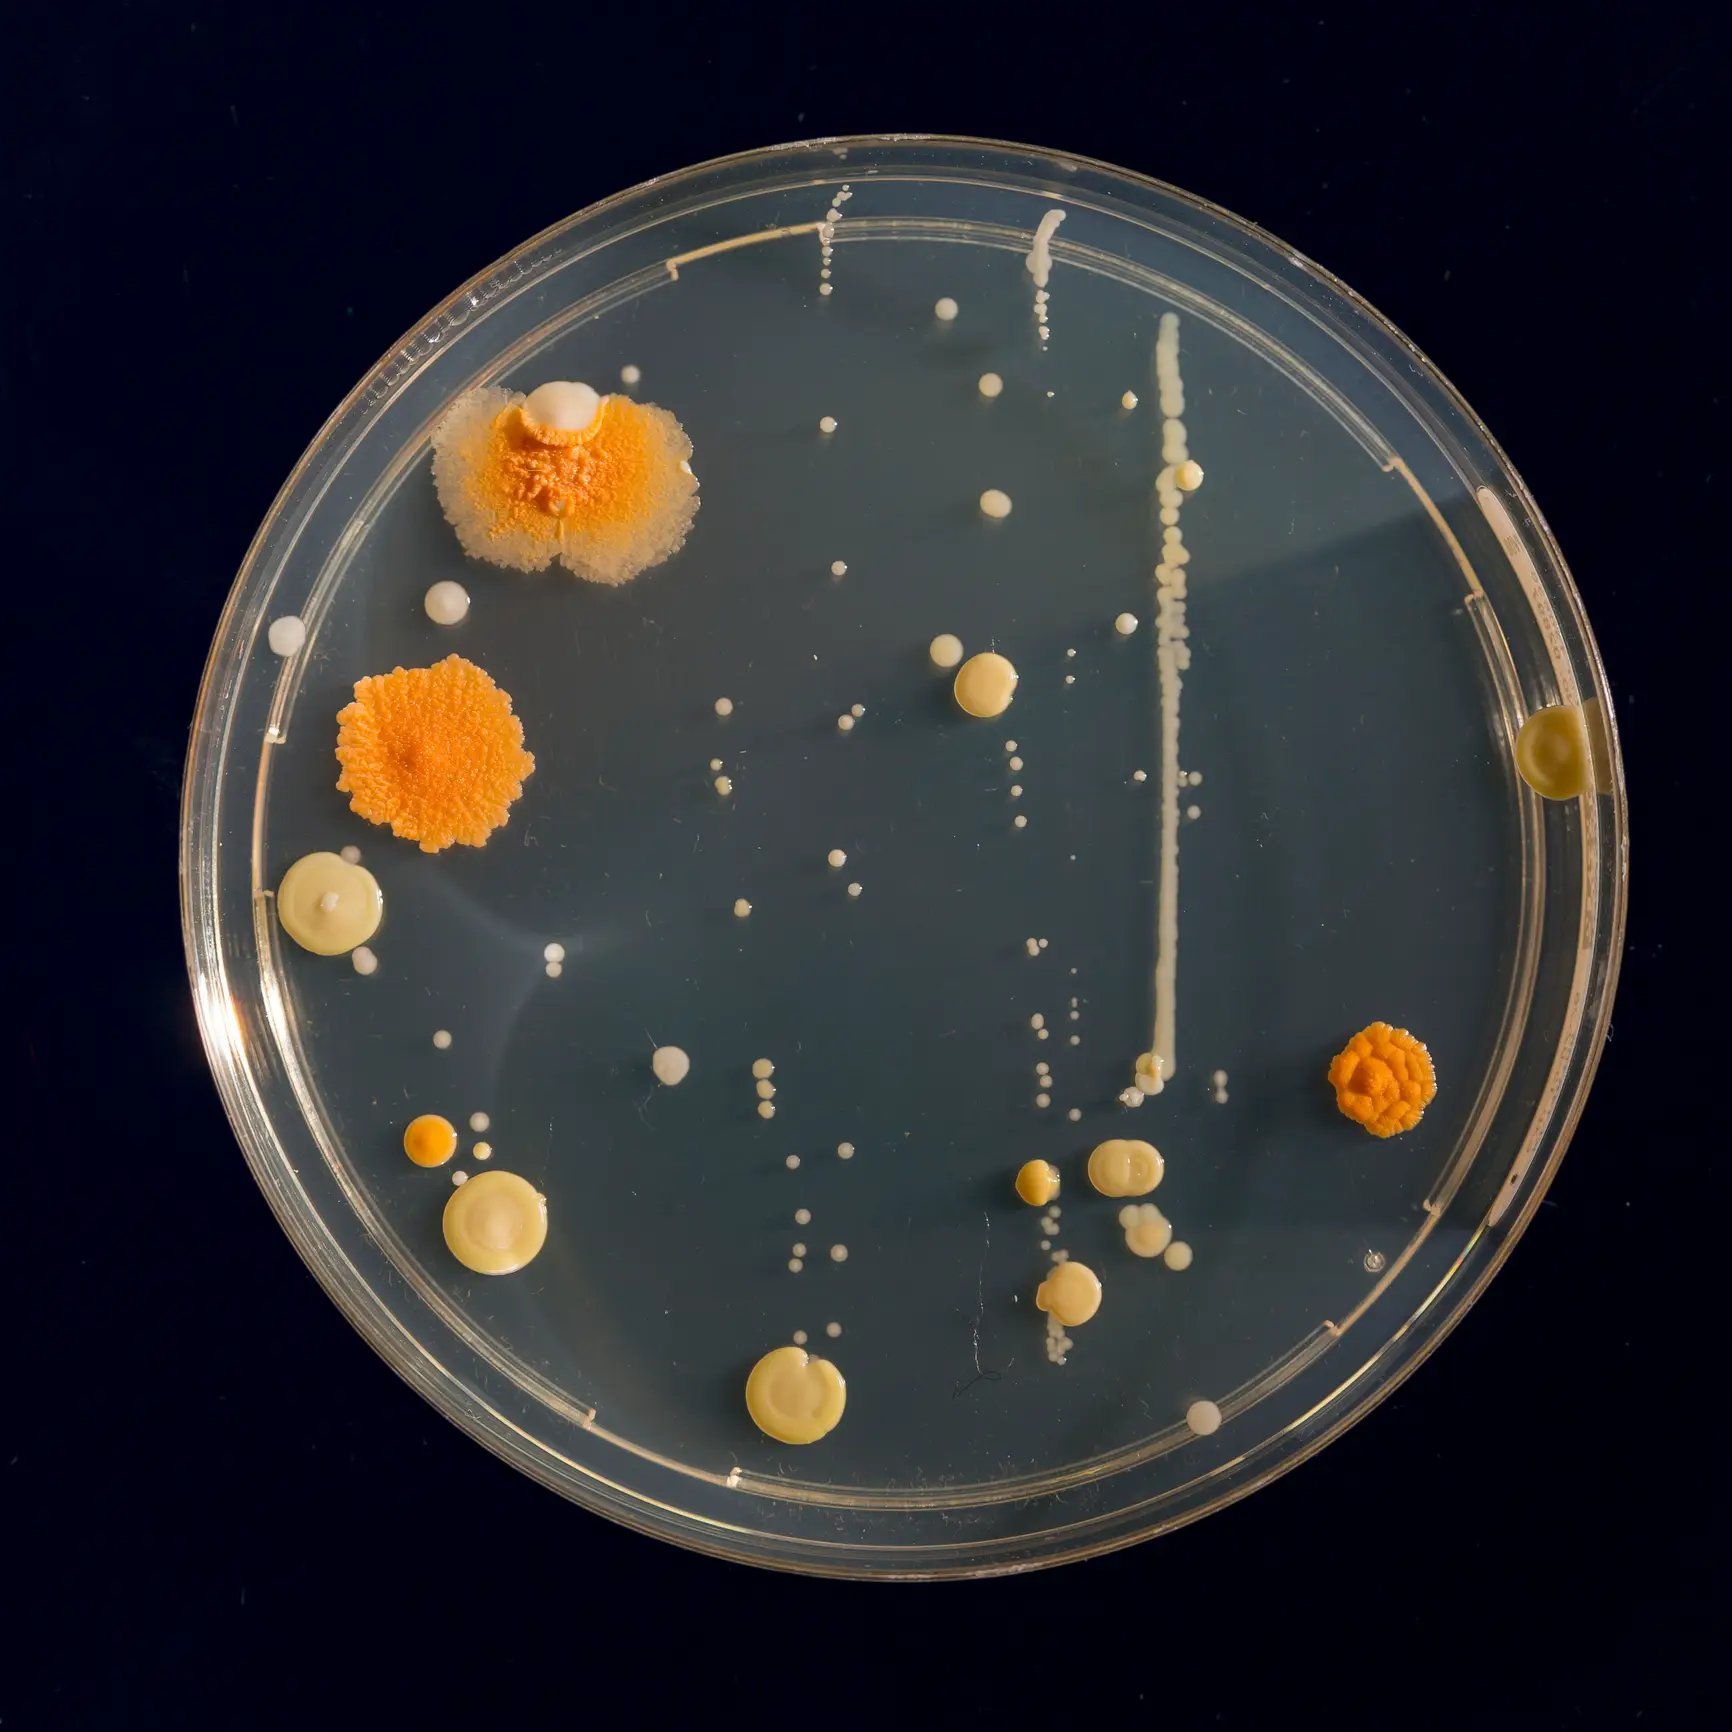
The fungus can live on peoples' skin without causing infection (Getty Stock Images)

Here are the symptoms of a potentially deadly fungal virus which is spreading throughout the continent.
Health officials across Europe have raised the alarm after noticing an uptick in cases of infections in hospitals caused by a fungus known as Candidozyma auris (C. auris) – a pathogen that has been recorded on every continent in the world, excluding Antarctica.
According to recent statistics, there has been 134 new cases of C. auris in the UK between November 2024 to April 2025, which is a 23 percent increase compared with the previous six months, according to UKHSA.
So what is the the fungal virus – and how dangerous is it?
Candidozyma auris explained
C. auris is a member of the yeast family. A recently discovered pathogen, it was first identified in a patient in Japan back in 2009.
Advert
Infections from the fungus have since been identified in over 40 countries worldwide.
The fungus primarily lives on the skin without causing symptoms, only becoming a problem if it enters into the body.
According to UKHSA, the fungus spreads through contact with contaminated surfaces, medical equipment or transmission from individuals who have the fungus present on their skin, called colonisation.
C. auris is said to thrive in hospitals, can survive on surfaces for weeks and is resist multiple treatments.
What are the symptoms of Candidozyma auris?
Symptoms associated with C. auris often vary, depending on the severity of the infection.
People carrying the fungus on their skin can often be unaware of colonisation. However, other patients can develop much more serious infections, in areas such as: the blood, brain, spinal cord, bones, abdomen, wounds, ears, respiratory tract, and urinary system.
So not quite a The Last of Us apocalyptic scenario, but something for healthcare workers to be concerned about.

Who is most at risk of Candidozyma auris?
People particularly susceptible to developing severe symptoms from C. auris infections are those with weakened immune systems, particularly those who've been in intensive care, hospitalised for an extended period of time or those on courses of antibiotics.
Methods to prevent the spread of C. auris include increasing awareness of hand hygiene, 'appropriate management' of patients and effective decontamination of medical equipment.
There are also concerns about the virus becoming resistant to anti-fungal medications, with the UKSHA adding: "C. auris represents a growing global health concern, particularly in healthcare settings where it can spread rapidly and resist treatment and some disinfectants. While not yet widespread in England, it is important that we remain aware that C. auris may spread in hospital environments.
"Through effective infection prevention and control measures, rigorous hygiene practices, ongoing monitoring and continued research, its spread can be minimised."